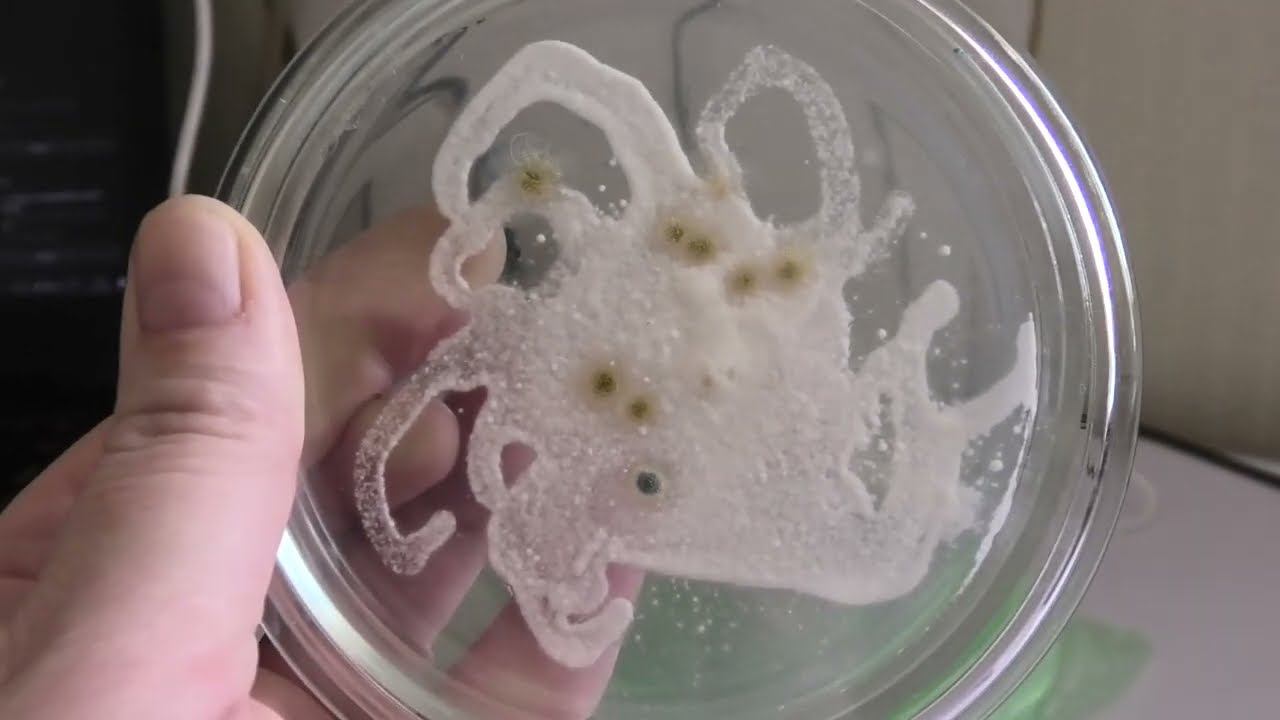
Проверяю био препараты из магазина на наличие заявленных грибов смотреть онлайн

Автор: Гречишникова Татьяна Страница 3

беглый осмотр как перезимовала ежевика

Впервые я с вами заговорила об очень важном! О ризофагии, периодах развития и микробиоте почвы!

Весна, любуюсь и вы полюбуйтесь со мной

Я увидела чудо на абрикосе полученном от Владимира Цыганова.

Завершаем отправки всех заказов которые должны уехать в Апреле. по плану 25.06 отправим всех.

Смешиваю все свои штаммы тоиходермы. пришло время вносить ее на участке.

Жимолость будет отправляться только в мае. Кратко о том почему я не использую удобрения .

О сроках рассылки для разных культур. Не пугаться если в посылке нет чего то в наличии.

открываем ежевику, мыши не съели но часть сортов погибла под укрытием из лоз.

вечерняя прогулка

Первые ласточки прилетели!

Посев чистой культуры на субстрат. Завершающий этап выращивания биопрепаратов, подробный рассказ

рассказываю о том как я выращиваю клубнику и готовлю почву под клубнику.

Первая партия посылок почтой России готова утром уехать. Встречайте.

Осматриваю молодые персики после зимовки 2023-2024 год Пензенская область р.п. Тамала.

Чистые культуры для засева на субстрат, осмотр разных штаммов триходермы на чашках петри.

начинаем упаковку ваших заказов. 8.04.2024 первая партия уйдет ТК СДЭК. 9.04.2024 Почта

Подготовка чашек перед стерилизацией упаковка на долгое хранение
Проверяю био препараты из магазина на наличие заявленных грибов

Как выглядит ТРИХОДЕРМА

Рецепт от Гречишниковой приготовления субстрата для выращивания биопрепаратов

Как вырастить грибные биопрепараты для своего сада и огорода

ирга сорт JB 30 и АЛЬТАГЛОУ

ирга сорта ПРИНЦЕССА ДИАНА и БАЛЛЕРИНА
За каждым успешным каналом стоит личность, идея и сотни часов кропотливого труда. Если вы здесь, значит, автор «Гречишникова Татьяна» уже сумел зацепить ваше внимание своим уникальным стилем или подачей. А мы на RUVIDEO позаботились о том, чтобы вы могли изучить весь архив его работ в максимально комфортных условиях — без лишней суеты и преград.
Почему за работами канала «Гречишникова Татьяна» так интересно наблюдать? Всё просто: это честный контент, который находит отклик в сердцах зрителей. На нашем ресурсе вы можете смотреть онлайн все видео любимого автора бесплатно и в хорошем качестве. Нам важно, чтобы вы видели каждую деталь и слышали каждый нюанс, поэтому мы используем только стабильные плееры из открытых источников Rutube.
Следите за новинками канала, пересматривайте старые шедевры и открывайте для себя новые грани творчества «Гречишникова Татьяна». Мы постоянно обновляем ленту, чтобы у вас под рукой всегда были самые свежие выпуски. Никаких сложных регистраций — только вы и творчество, которое вдохновляет. Приятного вам путешествия по миру авторского контента на RUVIDEO!
Видео взято из открытых источников Rutube. Если вы правообладатель, обратитесь к первоисточнику.